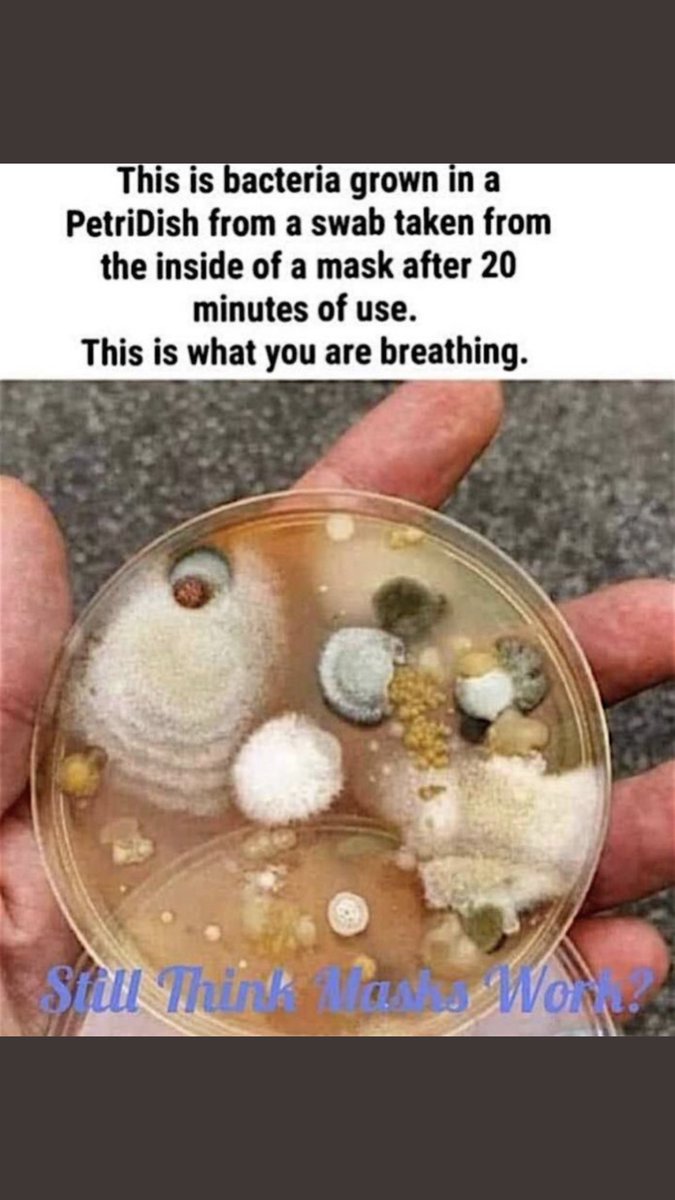
HeyHeiders's tweet image. @MichaelsStores masks do not prevent Covid in any documented way.  They do, however, prevent me from adding you to the list of store that will never get my money again. Furthermore teaching your employees to harass customers is wrong. #MasksDontWork #oxygenislife #mybodymyhealth

#oxygenislife search results
With @UNITAID funding, CHAI is proud to have been an implementing partner on this project to help increase the availability and access to oxygen to those who need it most. #InvestInOxygen #OxygenIsLife

2/10 Oxygen (O): The most abundant element in our bodies, making up about 65% of our mass! 🌬️ It's essential for respiration and is primarily found in water (H₂O)—about 60% of our bodies! #OxygenIsLife

In collaboration with @MOH_Kenya and health experts, @Jhpiego is strengthening oxygen infrastructure across Kenya to enhance healthcare delivery. #OxygenIsLife

🚨🚨progress update!! In 9 months we have generated enough oxygen capacity to treat over 14,000 patients a year! #investinoxygen #oxygenislife

@MichaelsStores masks do not prevent Covid in any documented way. They do, however, prevent me from adding you to the list of store that will never get my money again. Furthermore teaching your employees to harass customers is wrong. #MasksDontWork #oxygenislife #mybodymyhealth


Apparently @KufemaZimbabwe was on the news at 10 @eNCA - who saw it? #oxygenislife #OxERAs help keep Zimbabwe breathing. #covid19

.@NorthwesternEM c/o 2021 alum @AlexHerndon4 (and dani rojas) schooling us on altitude related illness at #EMConf! #OxygenIsLife

Anyone looking for 🎃 inspiration, look no further. 🫁 #spookylungs 🫁 #NotHavingOxygenIsScary #OxygenIsLife


IN ONE HOUR: Join CHAI’s VP of Essential Medicines, Zachary Katz and speakers from @USAID, @fhi360 and @UNITAID for a webinar on strengthening oxygen ecosystems in low- and middle-income countries. Register here: ow.ly/bwta50HCq95 #InvestInOxygen #OxygenIsLife

Everyone with breathing problems should ideally have an oxygen concentrator at home. To order a high-end Oxygen Concentrator, just call HCAH at 1800-102-4224 and we'll deliver it directly to your home. #oxygenislife #oxygenconcentrator #hcah

We need this planet to live, so let’s take care of it. #CelebrateWater #oxygenislife WaterCheck.biz pinterest.com/watercheck/sta…

#OXYGENISLIFE| DONATE LIFE CAMPAIGN FOR ACQUISITION OF MEDICINAL OXYGEN PLANT ✅ In homage to the memory of the victims of the COVID-19 pandemic, with your help, we will make a new medicinal oxygen plant a reality for Piura. 🔻bit.ly/3seoxCB

I read these beautiful lines today. Let's take a pledge to grow more trees. #RespectTrees #RespectMotherEarth #OxygenIsLife #FightOxygenCrisis @drvandanashiva @Manekagandhibjp

ThrowbackThursday: A month ago, Kufema donated oxygen therapy equipment to Norton Rapid Response Team. We're proud to support our frontline health workers: they save lives. We just provide tools and support to help them do so. #OxygenisLife #OxERAs #SavingLives #BreatheZimbabwe

In collaboration with @MOH_Kenya and health experts, @Jhpiego is strengthening oxygen infrastructure across Kenya to enhance healthcare delivery. #OxygenIsLife

2/10 Oxygen (O): The most abundant element in our bodies, making up about 65% of our mass! 🌬️ It's essential for respiration and is primarily found in water (H₂O)—about 60% of our bodies! #OxygenIsLife

Oxygen is life's breath, and trees are its lungs. Let's nurture and protect our forests, for they are our greatest allies in the fight against climate change and the guardians of our planet's oxygen supply. 🌳💚 #SaveTheTrees #OxygenIsLife
Cutting off oxygen to your brain was also unacceptable. How can we get it restored? #oxygenislife
With @UNITAID funding, CHAI is proud to have been an implementing partner on this project to help increase the availability and access to oxygen to those who need it most. #InvestInOxygen #OxygenIsLife

COVID-19 exposed the severe lack of medical oxygen in many LMICs. Devex spoke to Dr. Benoucheca Pierre, head of the ICU at Hôpital Universitaire de Mirebalais in Haiti, about the actions needed: bit.ly/3OfBlap #Sponsored by @PIH #oxygenislife #investinoxygen #BRINGO2
Anyone looking for 🎃 inspiration, look no further. 🫁 #spookylungs 🫁 #NotHavingOxygenIsScary #OxygenIsLife


Congratulations @BRING_O2 for this contribution towards #OxygenAccess . #OxygenIsLife , Let's #InvestInOxygen cz #EveryBreathCounts. @Stop_Pneumonia @JustACTIONS
🚨🚨progress update!! In 9 months we have generated enough oxygen capacity to treat over 14,000 patients a year! #investinoxygen #oxygenislife

🚨🚨progress update!! In 9 months we have generated enough oxygen capacity to treat over 14,000 patients a year! #investinoxygen #oxygenislife

Oxygen systems are complex. @PIH and @BRING_O2’s work prove that helping people breathe is more than worth the effort. Grateful to @UNITAID for investing these efforts. #InvestInOxygen #OxygenIsLife pih.org/article/infogr…
Boundaries….but in a place where dad and I can live in peace….with 2 oxygen tanks because at this point I’m just as old as he is #dadjokes #butimnotkidding #oxygenislife #heartissues
Distance is my new response. I don’t return energy, I simply remove myself.
Life-saving work by @SociosEnSalud. Thank you to @UNITAID for supporting us! #InvestInOxygen #OxygenIsLife @PIH
#COVID19 😷 I 𝗣𝗹𝗮𝗻𝘁𝗮 𝗱𝗲 #𝗼𝘅í𝗴𝗲𝗻𝗼 𝗱𝗲𝗹 𝗛𝗼𝘀𝗽𝗶𝘁𝗮𝗹 𝗦𝗮𝗻 𝗝𝘂𝗮𝗻 𝗱𝗲 𝗗𝗶𝗼𝘀 𝗱𝗲 #𝗖𝗮𝗿𝗮𝘇 - #Ancash 𝘃𝘂𝗲𝗹𝘃𝗲 𝗮 𝗲𝘀𝘁𝗮𝗿 𝗼𝗽𝗲𝗿𝗮𝘁𝗶𝘃𝗮.🤩 ✍🏽🔗Conoce más aquí: bit.ly/3FEfm6S 🤓 #plantaDeOxigeno #COT #LaInjusticiaTieneCura @PIH
With @UNITAID funding, CHAI is proud to have been an implementing partner on this project to help increase the availability and access to oxygen to those who need it most. #InvestInOxygen #OxygenIsLife

.@NorthwesternEM c/o 2021 alum @AlexHerndon4 (and dani rojas) schooling us on altitude related illness at #EMConf! #OxygenIsLife

IN ONE HOUR: Join CHAI’s VP of Essential Medicines, Zachary Katz and speakers from @USAID, @fhi360 and @UNITAID for a webinar on strengthening oxygen ecosystems in low- and middle-income countries. Register here: ow.ly/bwta50HCq95 #InvestInOxygen #OxygenIsLife

In collaboration with @MOH_Kenya and health experts, @Jhpiego is strengthening oxygen infrastructure across Kenya to enhance healthcare delivery. #OxygenIsLife

🚨🚨progress update!! In 9 months we have generated enough oxygen capacity to treat over 14,000 patients a year! #investinoxygen #oxygenislife

I read these beautiful lines today. Let's take a pledge to grow more trees. #RespectTrees #RespectMotherEarth #OxygenIsLife #FightOxygenCrisis @drvandanashiva @Manekagandhibjp

@MichaelsStores masks do not prevent Covid in any documented way. They do, however, prevent me from adding you to the list of store that will never get my money again. Furthermore teaching your employees to harass customers is wrong. #MasksDontWork #oxygenislife #mybodymyhealth

Everyone with breathing problems should ideally have an oxygen concentrator at home. To order a high-end Oxygen Concentrator, just call HCAH at 1800-102-4224 and we'll deliver it directly to your home. #oxygenislife #oxygenconcentrator #hcah

2/10 Oxygen (O): The most abundant element in our bodies, making up about 65% of our mass! 🌬️ It's essential for respiration and is primarily found in water (H₂O)—about 60% of our bodies! #OxygenIsLife

Anyone looking for 🎃 inspiration, look no further. 🫁 #spookylungs 🫁 #NotHavingOxygenIsScary #OxygenIsLife


We need this planet to live, so let’s take care of it. #CelebrateWater #oxygenislife WaterCheck.biz pinterest.com/watercheck/sta…

Low oxygen levels inside a human body are dangerous and can be life-threatening. So if your oxygen level falls below the normal range, immediately take medical consultation. #OxygenLevel #CovidOxygen #oxygenislife #nestivahospitaldelhi

Something went wrong.
Something went wrong.
United States Trends
- 1. Klay 21.2K posts
- 2. McLaren 69.7K posts
- 3. #AEWFullGear 70.9K posts
- 4. Lando 116K posts
- 5. #LasVegasGP 204K posts
- 6. Ja Morant 9,396 posts
- 7. Oscar 108K posts
- 8. Max Verstappen 57.4K posts
- 9. Piastri 47.9K posts
- 10. Hangman 10.2K posts
- 11. Samoa Joe 4,984 posts
- 12. Gambino 2,645 posts
- 13. LAFC 15.8K posts
- 14. Swerve 6,469 posts
- 15. #Toonami 2,843 posts
- 16. Kimi 44.7K posts
- 17. Utah 23.9K posts
- 18. Fresno State 1,016 posts
- 19. South Asia 34.6K posts
- 20. Rose Bowl 1,674 posts


























